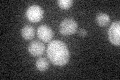
YCR092C
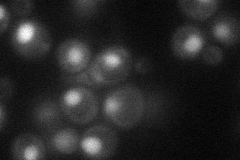
YCR092C
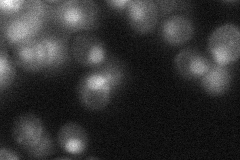
YCR092C
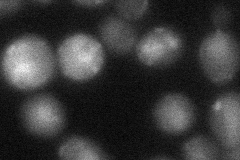
YCR092C
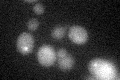
YCR092C

View description
Mismatch repair protein, forms dimers with Msh2p that mediate repair of insertion or deletion mutations and removal of nonhomologous DNA ends, contains a PCNA (Pol30p) binding motif required for genome stability
Localization:
Intensity:
Fold change:
Significance:
-
C’ GFP library in SD
below threshold18.38 -
N' NOP1pr-GFP in SD
nucleus37.6695 -
N' TEF2pr-mCherry in SD

nucleus338.567 -
N' NATIVEpr-GFP in SD
nucleus22.2987 -
N' TEF2pr-VC and Cyto-VN in SD
nucleus28.9035 -
C’ GFP library in SD+DTT
cytosol15.50.84No -
C’ GFP library in SD+H2O2

cytosol17.580.95No -
C’ GFP library in Starvation Media

cytosol17.10.93No -
C’ GFP library on the background of Pup2-DaMP

below threshold -
C’ GFP library on the background of CCT mutant

below threshold19.71831.07253No
